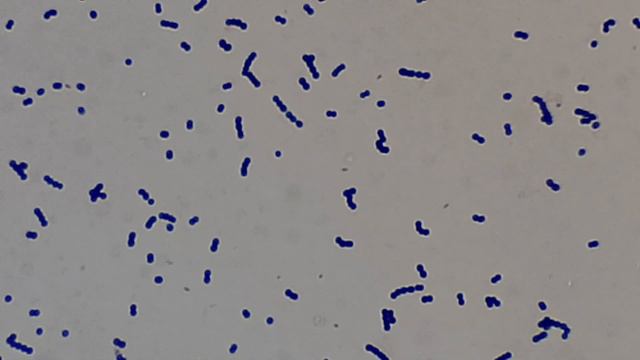

Enterococcus faecalis 2 кое
Enterococcus faecalis 2 кое 111 фотографий
Жк на шаболовской
Вархаммер chaos
Инвент джетроник 2.3
I 63.4 мкб
Объединение протеста
Магнитные бури утром сегодня
Рейтинг светодиодных уличных прожекторов
Что означает в смете зп эм
Вир школ
Маршрут поезда анапа москва 259
Косинус альфа равно 1 3
26.11 1982
Санитарная сумка со спецукладкой
Сайт гимназии 1 нальчик
Включи компота делают укол
Структура кодовое обозначение
Синдром движения конечностей
Просьба оплатить долги
Кроха жуковский
Карта осадков в нерехте костромской